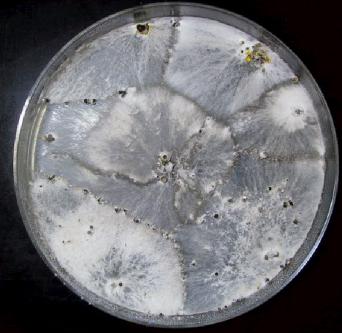
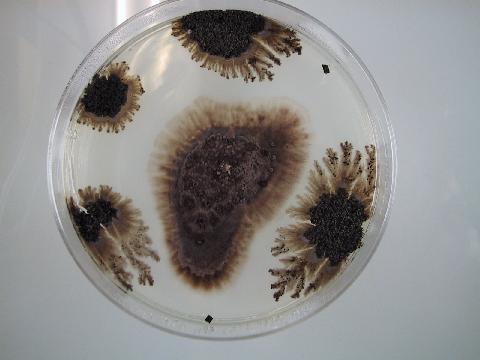

| -樹木の葉圏に生息する菌類(内生菌)- |
|---|


| -樹木の葉圏に生息する菌類(内生菌)- |
|---|

内生菌(endophytic fungi)は生きた植物の内部で病気を起こさずに生息する菌類のことです。 日本ではあまりなじみのない言葉ですが, 内生菌は世界的に注目を集め, 研究が盛んにおこなわれています。 比較的古くから内生菌の存在は知られていましたが, 重要なものではないと考えられていました。では, どうしてこの内生菌が注目されはじめたかといいますと, 家畜に対する中毒の原因が, 牧草内に存在する菌類であることが明らかになったためです。以来, 内生菌はイネ科やカヤツリグサ科, イグサ科などの 牧草類で約300種以上で研究がおこなわれています。牧草類では, 内生菌に感染している 植物は家畜毒性を持つこと, 病害虫に対して抵抗性を示すこと, 乾燥などの環境ストレスに強いことなど, 様々な研究がおこなわれています。例えば, 内生菌に感染した芝生は, その害虫であるシバツトガ に対して耐虫性を示すことが明らかにされています。これを利用し, 内生菌を植物へ人為的に感染させ, 農薬に代わる防除の一つとして利用する研究も行われています。 一方, 樹木の内生菌は, あまり研究がおこなわれていません。現在, 日本では, ブナ科, マツ科, ツツジ科の数樹種でその存在が知られているだけです。
そこで, 我々の研究チームは, 樹木の内生菌を探索し, 約30種の樹木に, 普遍的に内生菌が存在することを 明らかにしました。これは, 27年前に来日したキャロル夫妻が示した「日本の樹木には内生菌が豊富に 存在しているだろう」ということを裏付ける結果となりました。そして現在では, ブナ科樹木など, 日本の主要樹木の内生菌を探索するとともに, それらの機能(役割)の解明, また内生菌と 樹木病害発生との関係などを研究しています。 内生菌は, ヴェールに包まれ, ほとんど知られていません。これを解明していく価値は十二分にあると 私は考えています。
興味のある方は, 是非, この研究室へ! 吉橋 秀典
参考文献
畑 邦彦(1998)内生菌「ブナ林をはぐくむ菌類」(金子 繁・佐橋憲生 編), 文一総合出版, 東京, 86-114.